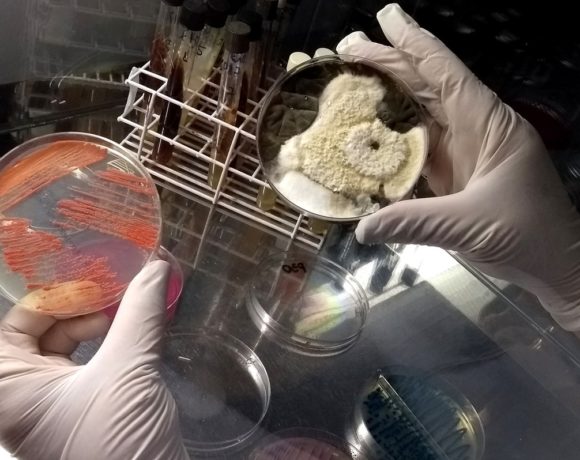

O INEP (Instituto Nacional de Estudos e Pesquisas Educacionais Anísio Teixeira) que pertence ao MEC, divulgou nesta terça-feira, 28 de novembro, no Diário Oficial da União os dados relativos a dois dos principais indicadores de qualidade da educação superior brasileira: o Conceito Preliminar de Curso (CPC) – indicador de qualidade que avalia os cursos de […]